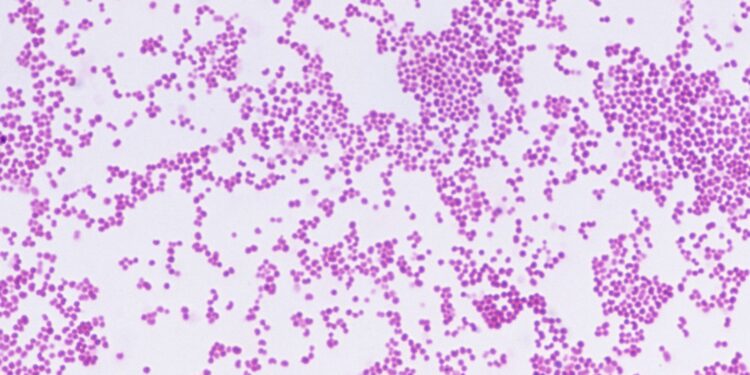
Meningitis-uitbraak in Kent waarschuwt jongeren voor risico’s

Een recente uitbraak van meningitis in Kent heeft opnieuw de aandacht gevestigd op het feit dat jonge mensen het meest kwetsbaar zijn voor deze ernstige infectie. Meningitis is een ziekte die wordt veroorzaakt door bacteriën die ontstekingen in de hersenen en het ruggenmerg veroorzaken. Het kan leiden tot ernstige complicaties, zoals hersenschade en zelfs overlijden.
De uitbraak in Kent heeft verschillende jonge mensen getroffen, waarbij sommigen op de intensive care moesten worden opgenomen. Deze tragische gebeurtenissen dienen als een harde herinnering aan het feit dat jonge mensen het meest vatbaar zijn voor meningitis. Dit komt omdat hun immuunsysteem nog in ontwikkeling is en ze vaak in nauw contact staan met anderen, waardoor de bacteriën gemakkelijk kunnen worden overgedragen.
Het is belangrijk voor jonge mensen om zich bewust te zijn van de symptomen van meningitis, zoals plotselinge koorts, hoofdpijn, nekstijfheid en overgeven. Als deze symptomen optreden, is het van cruciaal belang om onmiddellijk medische hulp in te roepen. Snelle diagnose en behandeling kunnen het verschil maken tussen herstel en ernstige complicaties.
De beste manier om meningitis te voorkomen is door middel van vaccinatie. Het meningitisvaccin is opgenomen in het Rijksvaccinatieprogramma en wordt aanbevolen voor alle jonge mensen. Door zich te laten vaccineren kunnen jonge mensen zichzelf beschermen tegen deze potentieel dodelijke ziekte.
Hoewel de recente uitbraak in Kent een tragische herinnering is aan het feit dat jonge mensen het meest kwetsbaar zijn voor meningitis, is het belangrijk om te benadrukken dat de ziekte relatief zeldzaam is. Met de juiste voorlichting, vaccinatie en snel ingrijpen bij symptomen, kunnen de risico’s worden geminimaliseerd en kunnen ernstige complicaties worden voorkomen.
Het is essentieel dat jonge mensen en hun ouders zich bewust zijn van de gevaren van meningitis en de stappen die ze kunnen nemen om zichzelf te beschermen. Door alert te zijn op symptomen, snel medische hulp in te schakelen en zich te laten vaccineren, kunnen jonge mensen zichzelf beschermen tegen deze ernstige infectie.